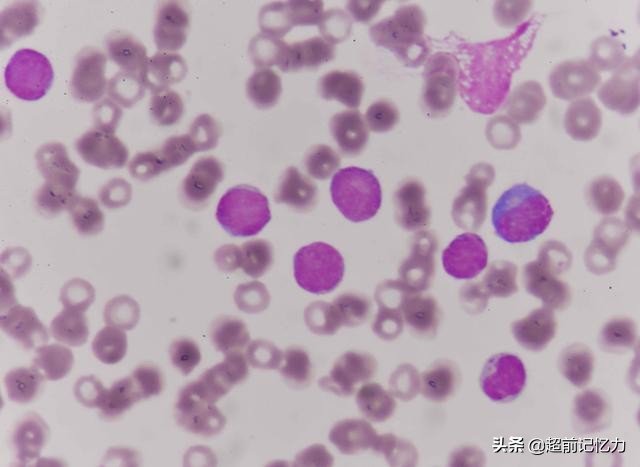
怎样去除老人味的最有效办法,老人味从何而来如何去除老人味

随着生齿老龄化的加快,暮年人的比重越来越高。在与暮年人的打仗中,我们发明很多暮年人有一种特殊的气味,也就是常说的“老人味”,这类局面非常常见。

“老人味”给人不太舒服的感觉,尽管不会给老人身材带来很大的作用,但会作用到老人的生活,或许会让周围的人产生不适的感觉。

很多老人认为这是到达必定年龄产生的特殊气味,并且这类味道是没法消除的,底下让我们来了解产生“老人味”的原因和去除“老人味”的方法吧。
为何会产生“老人味”呢?

1、细菌的繁衍。随着年龄的拉长,老人身材的性能会变弱、常见的是新陈代谢速率降低、肠胃消化能力和脏功能逐渐缓慢,这些都很容易造成细菌豪爽繁衍,接续的繁衍会造成细菌聚集,自然就会产生“异味”。

2、皮肤散发的气味。暮年*皮人**肤的抗氧化物质变少,激素也会产生变革,皮肤会渐渐排泄少许叫2-壬烯醛的物质,气味不好闻,很像是草地和脂肪汗液的混合体,如果对皮肤清洁不敷,更会加重这类气味。

3、口腔散发的气味。很多暮年人要面临缺牙、烂牙的状况,尚有些暮年生齿胃较重,常吃辛辣刺激的食品,更有些暮年人喜好抽烟饮酒,再加上对口腔清洁不敷,所以口腔很容易散发出“异味”。

4、*体下**散发的味道。很多暮年女性会浮现尿*禁失**和阴道炎,而暮年男性也容易得了前列腺增生,尿渍沾在衣物上,不实时冲洗,也会散发味道。

5、病症导致。好多暮年人会得了慢性病症,如得了老慢支、肺气肿,时常咳痰自然会有不太好闻的味道。尚有暮年人会得了暮年关节炎,他们时常贴膏药和涂抹药膏,时间久了也会散发气味。
去除“老人味”小妙招
1、勤清洁。首要是勤冲凉,勤换衣物,勤清算口腔。暮年人本身新陈代谢就较慢,更要加强冲凉的频率,常换衣物。
同期暮年人牙齿状况不太好,应当非常留意实时清洁口腔,防止口腔细菌的滋生,起码保证天天早晚两次刷牙,按期去口腔科做相关调养。
养成好的风俗,从生活中的清洁细节上尽或许减轻“老人味”的状况。
2、戒烟、戒酒、养成好的饮食风俗。抽烟会使口腔有浓浓的焦油味,身上也会感染久久不行散去的味道,而饮酒也会带来口腔异味。
这两者同期会作用康健,作用肝脏和肾脏的功能,器官遭到危害自然会导致细菌滋生,导致恶性循环。
在平时饮食中,多吃清淡的食品,尽力少吃或不吃浓重和过甜的食品,防止体内脂肪氧化加快的状况。
3、医治病症。身材的病症也会导致“老人味”的产生,实时去病院就诊,接纳科学的方法医治病症,使身材处于康健的状况,“暮年味”的状况自然会大大改善。
暮年人的“老人味”与本身的身材和清洁息息相关,暮年人可以从勤清洁、戒烟、戒酒、养成好的饮食风俗和医治病症入手,明晰偏向,有针对性淘汰“老人味”的状况。当作老人的家属不可厌弃老人,应当帮助他们找到产生“异味”的首要原因,然后对症下药。
如果喜欢我的文章,请大家多多“关注”我吧,第一时间获取最新资讯!